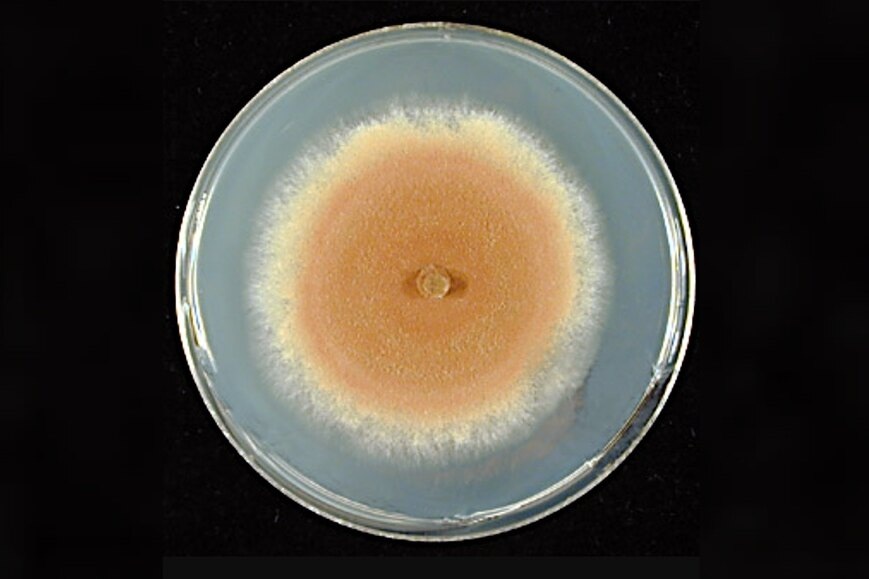

Исследования, проведенные коллективом из Института науки и технологий Окинавы (OIST), произвели настоящий фурор в понимании эволюции экосистем на Земле. Ученые установили, что грибы начали осваивать сушу за сотни миллионов лет до появления первых наземных растений, подготавливая континенты к их появлению.
Раскрытие тайны грибной эволюции
Молекулярные часы, используемые для оценки временных рамок эволюции, основываются на анализе накопления мутаций в ДНК, осуществляется сравнением генетических различий между видами. Эти часы требуют калибровки с использованием окаменелостей; горизонтальный перенос генов, позволяющий передавать генетический материал между неродственными организмами, помог установить временные ограничения для расхождения видов. Таким образом, донорские виды должны существовать до реципиентских.
Сложные многоклеточные формы жизни, такие как животные и грибы, возникали на Земле несколько раз, каждая из групп оставила свои следы в виде окаменелостей. Однако грибы долго оставались загадкой из-за своей мягкой структуры, которая плохо сохраняется в ископаемых. Научная команда OIST решила эту проблему, внедрив новый метод — анализ горизонтального переноса генов между различными грибами.
Новооткрытые временные связи
С помощью 17 идентифицированных переносов генов, исследователи создали новую временную шкалу для грибов. Установлено, что общий предок современных грибов жил примерно от 1,4 до 0,9 миллиарда лет назад, значительно раньше, чем появились наземные растения. Доктор Ленард Сантхо, один из авторов исследования, отметил, что грибы играли ключевую роль в экосистемах, обрабатывая питательные вещества и взаимодействуя с водорослями, создавая таким образом основу для будущих экосистем.
Новая перспектива на колонизацию суши
Полученные результаты кардинально изменяют понимание процесса колонизации суши. Протяженные миллионы лет грибы разрушали породы, формируя первичные почвы и изменяя континенты, при этом растения не находили разрушительной пустоши, а входили в мир, подготовленный древними грибами, обладавшими своей экосистемной властью.